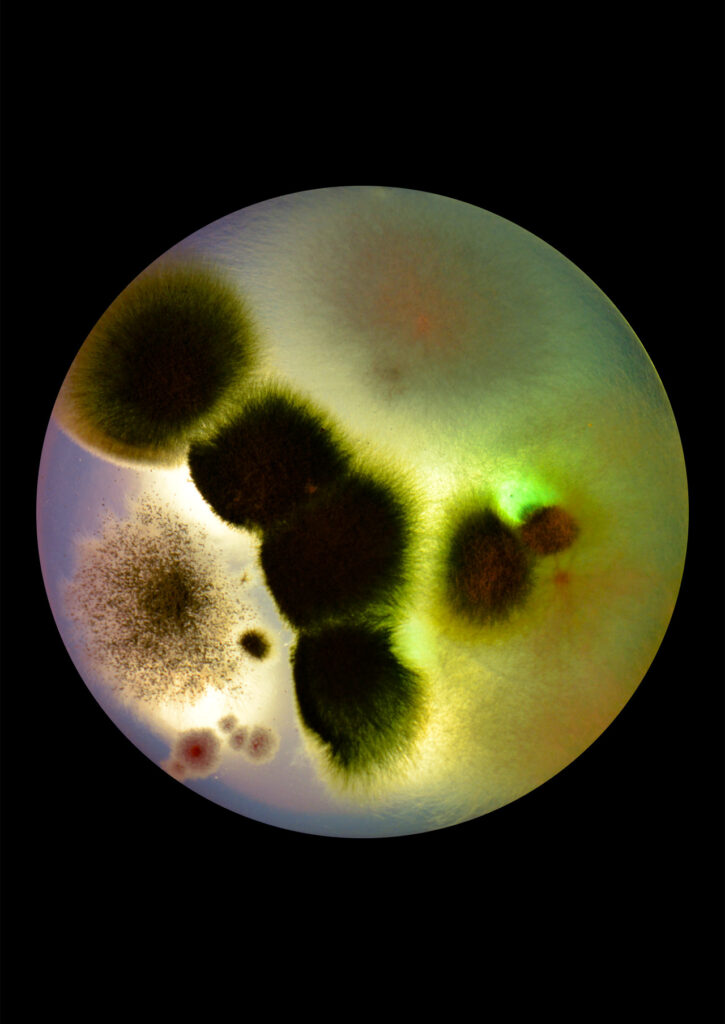
Flourish and Fungi IV by Lianne Regtuit print 7 Flourish and Fungi IV by Lianne Regtuit print 7
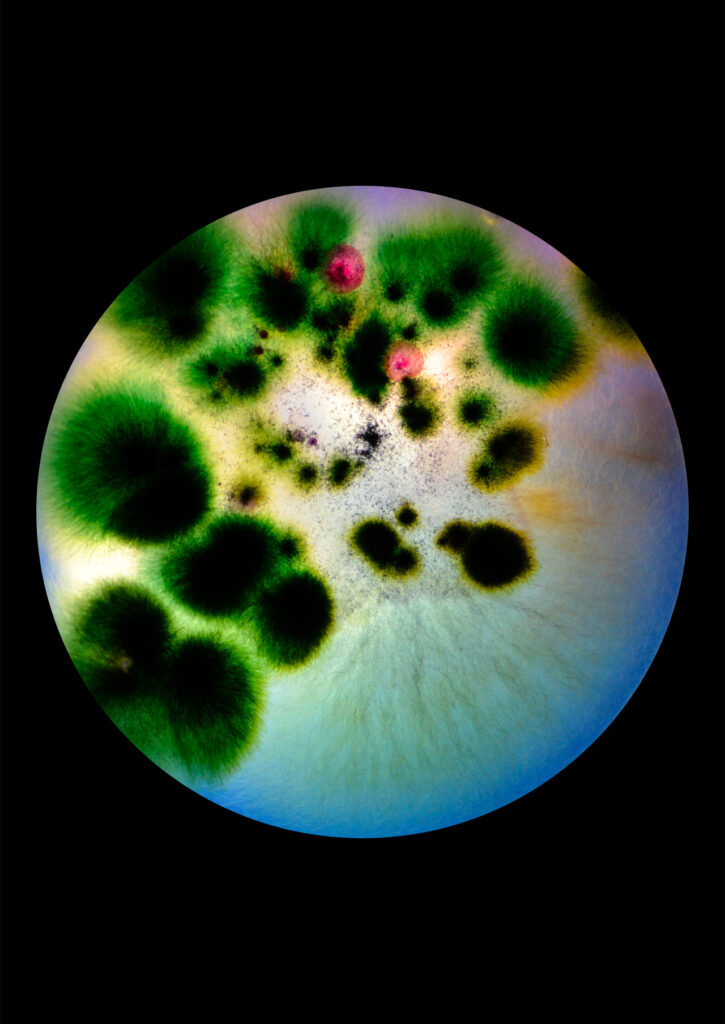
Flourish and Fungi IV by Lianne Regtuit print 8 Flourish and Fungi IV by Lianne Regtuit print 8
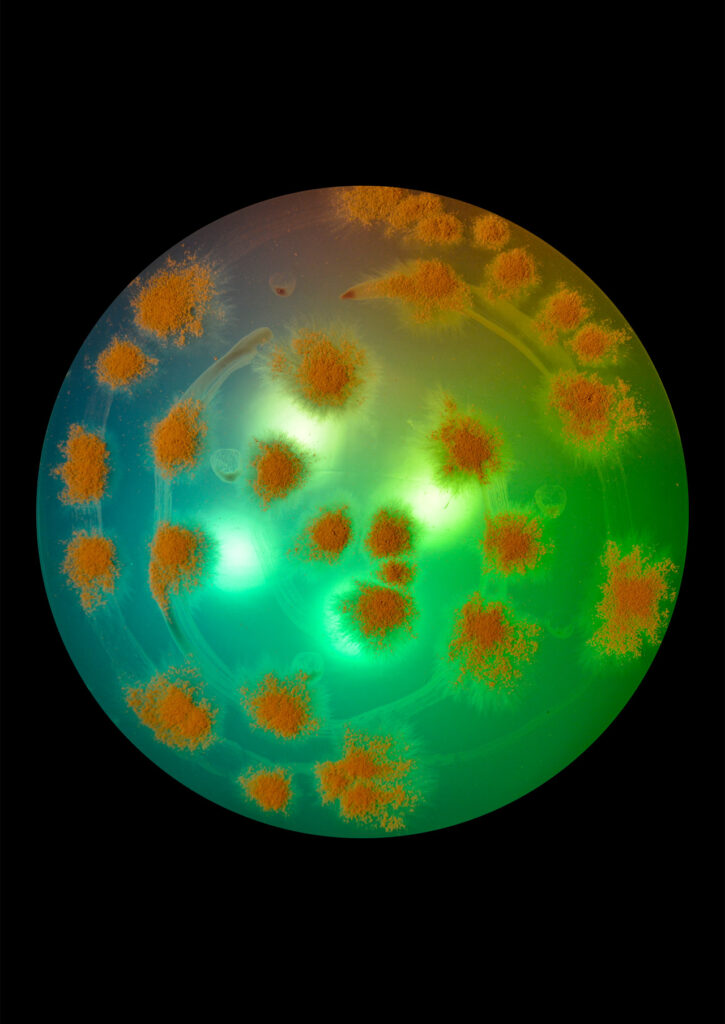
Flourish and Fungi IV by Lianne Regtuit print 6 Flourish and Fungi IV by Lianne Regtuit print 6
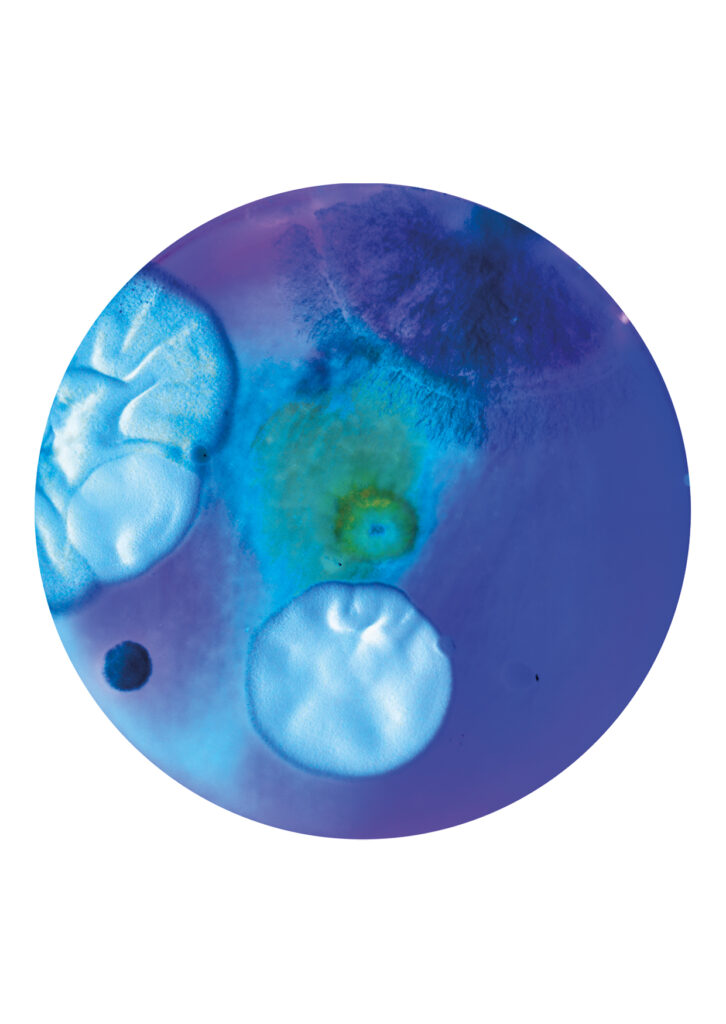
Flourish and Fungi III Inverted by Lianne Regtuit Microbial print 2 Flourish and Fungi III Inverted by Lianne Regtuit Microbial print 2
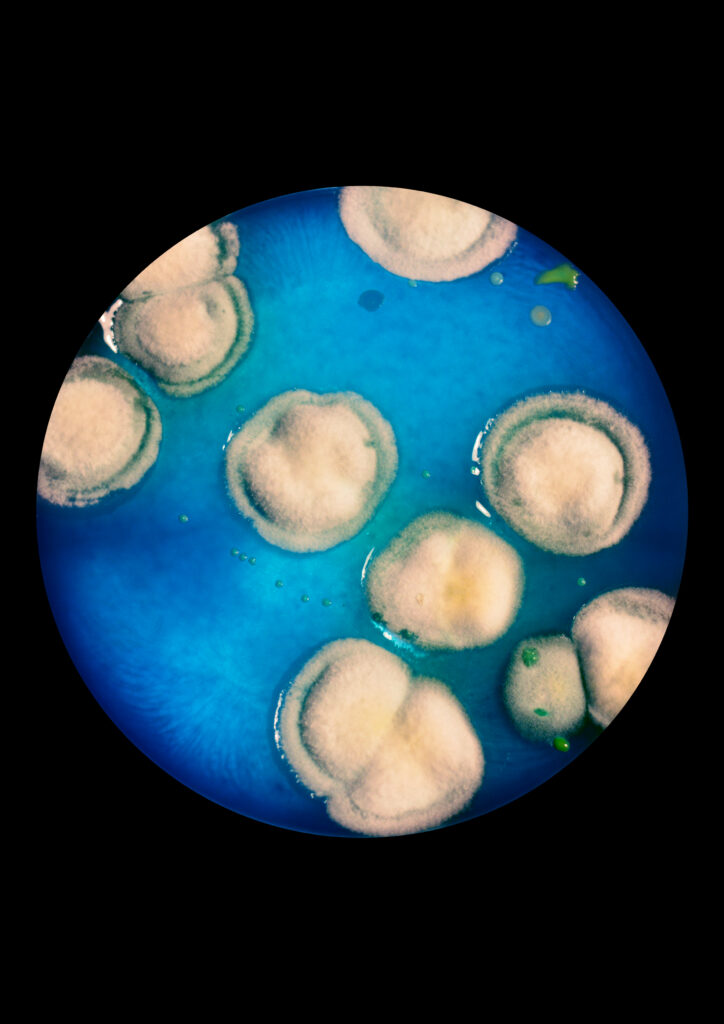
Flourish and Fungi II by Lianne Regtuit Microbial print 6 Flourish and Fungi II by Lianne Regtuit Microbial print 6
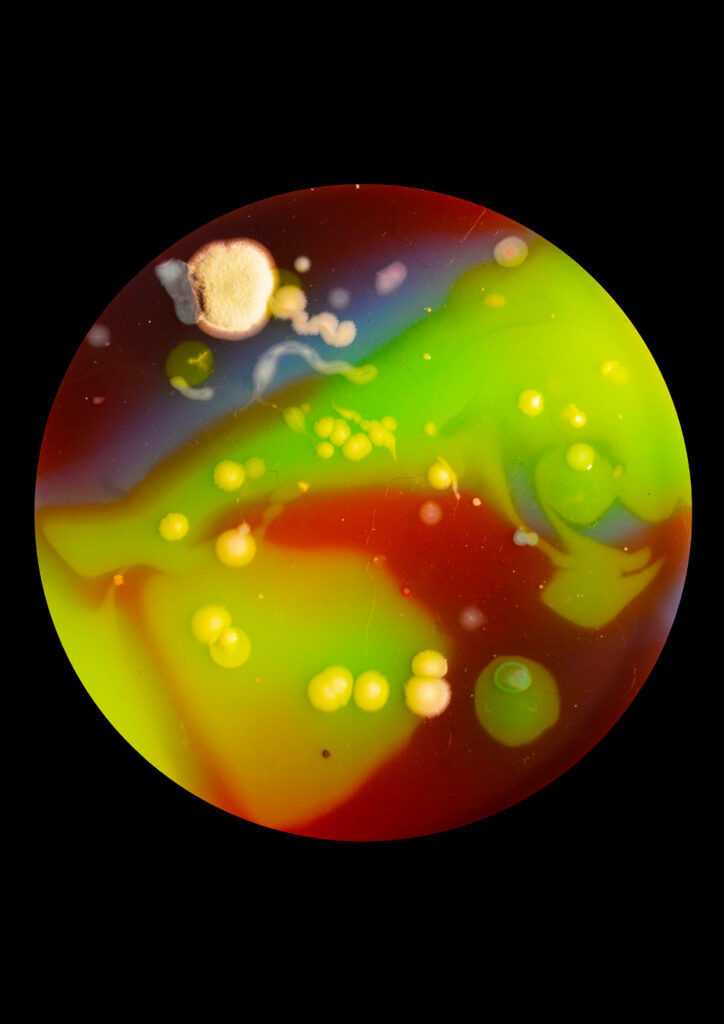
Flourish and Fungi II by Lianne Regtuit Microbial print 8 Flourish and Fungi II by Lianne Regtuit Microbial print 8
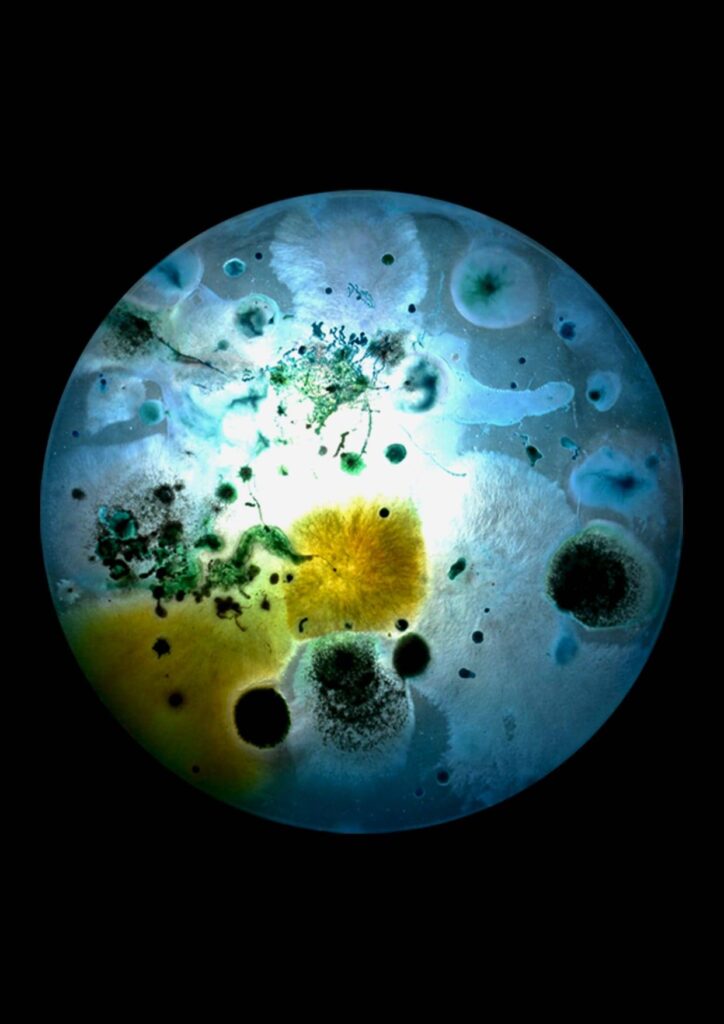
Flourish and Fungi I by Lianne Regtuit Microbial print 1 Flourish and Fungi I by Lianne Regtuit Microbial print 1

Flourish & Fungi
A Photographic Journey into Microbial Worlds
by Lianne Regtuit
Biobased design
Photographic print series
Microbiology
Bacteria cultivation
With this project, I aim to highlight the often-underappreciated beauty and immense importance of this microscopic world.
By making the invisible visible, I want to eliminate ignorance and offer a new perspective.
Many people are unaware of the biodiversity nature holds and often associate bacteria and fungi with negativity, while these organisms are in fact vital to all life on Earth. Through my work, I seek to inspire admiration, shifting perceptions of the microbial world. Ultimately, I hope my work contributes to a more harmonious and caring human attitude toward nature.
My artworks are a way for me to make the invisible visible, by collecting traces of ourselves and the world around us. It is a collaboration between myself, time, and Mother Nature.
The Process
I begin by cooking a nutrient medium, with agar as its base. Over the course of a previous semester, I dedicated myself to exploring different recipes and conducting countless experiments to find the ideal composition. This was a valuable process in which I not only honed my practical skills but also greatly expanded my knowledge of microbiological techniques.
Once the nutrient media are prepared and colored, it’s time to paint my canvases. This process brings a rush of adrenaline, as I have only a few minutes before the medium transitions from liquid to solid. I must quickly make decisions about composition, color, accents, and layering.
The next step is to invite Mother Nature into the process by collecting spores from various sources knowing that bacteria are everywhere. What exactly my samples will produce, and how they will develop, remains a surprise. Time plays a crucial role, as the image continuously changes and is ultimately ephemeral. Patient observation is essential, as nothing can be predicted. It can take up to two weeks for the bacteria and fungi to reach their peak when the moment is right to capture them. With the right timing, I’m able to preserve the image at its perfect stage, either through photography or by fixing and preserving it.
Flourish & Fungi
This process has resulted in a photographic series titled Flourish & Fungi. In this series, you see photographic prints of the bacteria I cultivated on my self-developed nutrient medium. Each print is a snapshot of the collaboration between myself, time, and Mother Nature: a visual story of growth and transformation.
FLOURISH & FUNGI IV
FLOURISH & FUNGI III (INVERTED)
FLOURISH & FUNGI II
FLOURISH & FUNGI I
Lianne Regtuit
Biobased Art & Design
Contact
Do not hesitate to contact me to discuss a possible project or learn more about my work.
© 2025 Lianne Regtuit